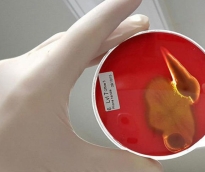
alsharq

أصدرت الخطوط الجوية القطرية توضيحًا بشأن مقطع فيديو متداول على وسائل التواصل الاجتماعي يُظهر طائرة شحن تحمل ألوان وشعار الشركة وهي تنفذ تحليقًا...
رئيس مجلس الإدارة : د. خالد بن ثاني آل ثاني

رئيس التحرير: جابر سالم الحرمي

مساحة إعلانية

تثبت الدلائل أن استمتاعك بالتمارين الرياضية قد يكون له علاقة بموروثاتك، فقد أثبتت التجارب التي أجريت على مجموعتين معدلتين وراثياً من الفئران أن إحدى المجموعتين كانت أميَل لممارسة التمارين الرياضية أكثر من الأخرى. إذا كان هناك أي سبب يمنع الناس عن ممارسة التمارين الرياضية، فهو ليس عضوياً بقدر ما هو ذهني، لذا صحح منظورك الذهني وتقدم وفق الخطة التالية: حدد الهدف من التمرين يقع العديد في خطأ ذهني رئيسي، فحين يتعلق الأمر بالنشاطات الصحية، يبدأ الناس بالتفكير في الركض أو حتى المشاركة في ماراثون، "يجب أن أخفف وزني... يجب أن أبدأ بالركض، يجب أن أكتسب مرونة أكثر وأتخلص من آلام الظهر.. يجب أن أنضم إلى سباق الماراثون". بالطبع هناك أسبابٌ طبيعية لجعل الركض الخيار الأول، ليس فقط بسبب سهولة ممارسته، بل أيضاً لأنه شائعٌ اجتماعياً، لكن هذا خطأ شائع. في الحقيقة، ولأن معظم الناس يبدؤون بممارسة التمارين الرياضية بسبب اكتساب وزن زائد، قد يكون الركض هو الخيار الأسوأ، فهو شاق ومؤلم لذوي الوزن المفرط، وينطبق الأمر نفسه على التمارين المخصصة لحرق السعرات الحرارية، التي غالباً ما تفشل في تحقيق أهدافها. لا يعني هذا أن الركض رياضة غير مفيدة، اركض إن كنت تحب الركض، إن لم يكن هاجسك الأساسي هو فقدان الوزن، أو إن كنت تريد زيادة قدرتك على بذل الجهد، لكن إن كان فقدان الوزن هو الأهم بالنسبة لك أو إن كنت تكره الركض، فالأجدر أن تفكِّر بأنماط أخرى من التمارين مثل المشي. المحفزات حين تختار رياضةً معينة، سواءً كانت اليوجا أو الملاكمة أو أي رياضةٍ أخرى، حاول أن تكتشف الإنجاز الذي سيحفزك أكثر، مثلاً، زيادة عدد تمارين الضغط إن كنت تمارس رياضات القوة، أو تقليص الزمن الذي تستغرقه لقطع مسافة معينة إن كنت تمارس الركض. أحد الطرق للقيام بهذا يُعرف بمبدأ "التفعيل"، أي تلك الكلمة السحرية التي تجعل شخصاً ما يقوم باستخدام منتجٍ معين بشكل متكرر، ينطبق الأمر على التمارين الرياضية، فما إن "تتعلق" بالرياضة حتى تبدأ بتكريس نفسك لها. التحسين ما أن تحدد آلية التفعيل، ابدأ بالعمل على التحسين، راقب عدد تمارين الضغط التي تقوم بها في كل مجموعة أو الزمن الذي تستغرقه لقطع مسافة ميل، تأكد أنك تبذل جهداً كافياً. الخطوة التالية هي التسجيل في برنامج خاص بتدريب المبتدئين، فقد حان وقت الحصول على إرشادات احترافية، لكن تأكد من أن البرنامج الذي اخترته ينسجم مع آلية "التفعيل" الخاصة بك. بعد أسبوع، قم بقياس تقدمك، ستجد تحسناً على الأغلب، إن لم يحدث هذا، فكر بالتمرين على أنه مشكلة موضوعية وحاول معرفة مكمن الخطأ. لم يستغرق الأمر أسابيع أو أشهر، لقد أنجزت كل شيء خلال أسبوع واحد تقريباً. احتفل بهذا ولا تنس أنك مبتدئ.
1309
| 02 نوفمبر 2015

تعتزم شركة تصنيع أدوية في اليابان إصدار أول دواء في العالم قد يمكنه أن يعالج الإنسان من مرض الإنفلونزا "نزلات البرد" خلال يوم واحد فقط. ويعتبر الدواء الجديد على عكس نظائره الموجودة في الأسواق، فهو يمنع انتشار فيروس الإنفلونزا ويقتله، كما أن هذا المستحضر يمنع أيضاً الفيروس من دخول الأنزيمات اللازمة لتكاثره. وبسبب هذا ومن أجل الشفاء التام يكفي أخذ مستحضر الدواء هذا ليوم واحد فقط، وفقا لما ذكرته صحيفة "نيكي" التي أشارت إلى أن الدواء قد مر بالفعل من خلال التجارب السريرية الأولى في اليابان، حيث أظهر فعاليته. وستبدأ المرحلة الثانية من التجارب، في نوفمبر، عندما يرتفع عدد حالات المصابين بالإنفلونزا بشكل كبير. وسيتم اختبار الدواء بالفعل على عدة مئات من المرضى، وترى وزارة الصحة اليابانية، أنه وبعد التأكيد النهائي من فعالية وسلامة الدواء واستكمال الإجراءات اللازمة لترخيصه، فإنه من الممكن أن يبدأ بيع الدواء فعلياً في عام 2018.
407
| 02 نوفمبر 2015

نصح أطباء وأخصائيو تغذية الشباب تناول الفواكه والخضروات بكثرة، لكي لا يصابوا بأمراض القلب في المستقبل. وبينت نتائج دراسة علمية جمعت في عام 1985 معلومات عن أكثر من 2500 شخص "18-30 سنة" تشمل نوع غذائهم وحالتهم الصحية، كما قسم العلماء هؤلاء إلى 3 مجموعات استنادا لكمية الفواكه والخضروات التي يتناولونها. وضمت المجموعة الأولى الذين يتناولون 7- 9 حصص من الفواكه والخضروات، والمجموعة الثانية الذين يتناولون كميات قليلة من 2.5 إلى 3 حصص، بينما المجموعة الثالثة تتناول الفواكه والخضروات أقل من أفراد المجموعة الأولى وأكثر من أفراد المجموعة الثانية. وخضع جميع المشتركين في هذه الدراسة في عام 2005إلى التصوير بالرنين المغناطيسي لتحديد مستوى تراكم الكالسيوم في الأوعية الدموية للقلب، اتضح من هذا الكشف، أن كمية الكالسيوم المتراكمة عند أفراد المجموعة الأولى أقل بنسبة 26% من أفراد المجموعة الثانية، أي أنهم أقل عرضة للإصابة بأمراض القلب.
1004
| 01 نوفمبر 2015

حذر أطباء وخبراء تغذية حول العالم السيدات من وضع الخبز داخل الثلاجة نهائيا، ثم إعادة تناوله لاحقا. قد يبدو هذا الأمر غير بديهي، حيث أن اختراع الثلاجات كان لمساعدة البشر في الحفاظ على نضارة الطعام، إلا أن تفسير ذلك يكمن في تعقيدات دورة حياة الخبز نفسها، فهو ينتج ساخنا في البداية ثم يبرد. والذي يحدث هنا هو أن النشويات الموجودة في الخبز يعاد ترتيب جزيئاتها في ظل السخونة الشديدة لدى عملية الخَبز، وعندما يبرد الخُبز تعود هذه الجزيئات إلى ترتيبها الأصلي، وهو الأمر الذي يُحول الخُبز تدريجيا إلى مرحلة الصلابة وفقدان النضارة ثم التعفن. أما عند وضع الخبز في الثلاجة، فكل ما يحدث هنا هو أنك تسرّع وتيرة هذه العملية، أي إعادة ترتيب جزيئات النشاء كما في وضعها الأصلي، ما يُسرّع تحول الخبز إلى مرحلة فقدان النضارة ثم التعفن. وعند الحاجة إلى تخزين باقي الخبز فترة طويلة، ينصح الخبراء بوضعه في وعاء محكم الغلق أو لفه في كيس بلاستيك بعناية، ثم وضعه في فريزر الثلاجة لتجميده، وعند الحاجة إليه، ينصح بتركه فترة قليلة حتى ذوبان الثلج منه تماما، ثم يمكن إعادة تسخينه وتناوله مرة أخرى. وينصح الأطباء وخبراء التغذية بالابتعاد عن شراء الخبز المُقطع على شكل شرائح، وشراء رغيف الخبز مكتملا، ثم قطع شرائح منه حسب الحاجة، لأن تقطيع الأرغفة إلى شرائح يقلص عُمر الخبز.
1000
| 30 أكتوبر 2015

تمكّنت الفتاة السعودية "عهود" من الأكل، بعد أن حرمت منه لمدة 10 سنوات، عاشت خلالها على السوائل، بعد جراحة ناجحة أجرتها في الهند الأسبوع الماضي. وذكرت صحيفة "ميد داي" الناطقة بالإنجليزية، اليوم الخميس، أن الفتاة، عهود عبدالحميد الضهيري "13 عاماً"، التي تعيش في مكة المكرمة، عانت منذ أن كانت في الثالثة من عمرها، من حالة نادرة تمنعها من تناول الطعام، بسبب وجود ورم حميد في المريء باتساع 12 سنتيمترًا، أدى إلى انسداد في المريء ومضاعفة حجم قلبها. وقالت الصحيفة، إن أسرة الفتاة سافرت لعديد من الدول العربية لإيجاد علاج لابنتهم، إلا أن أطباء في دول عربية ولكن لم تفلح، وأخيرًا قررت الأسرة التوجه إلى الهند، حيث تم إجراء جراحة دقيقة للفتاة في معهد الأورام في "مومباي". وأضافت الصحيفة، أن الفتاة حققت حلمها في الأكل، واحتفلت بأول وجبة لها، بعد 8 أيام من إجراء العملية، حيث تناولت قطعة من كعكة الشكولاتة، بعد عاشت طيلة السنوات العشر لا تتناول سوى الآيس كريم.
278
| 29 أكتوبر 2015

يصيب مرض القوباء الجلدي "الهربس"، نحو ثلثي سكان العالم ممن تقل أعمارهم عن الخمسين عاما، والمرض يتسبب يتسبب في ظهور قروح حول الفم. وأعلنت منظمة الصحة العالمية هذه الإحصائية في أول دراسة من نوعها تجريها المنظمة حول مدى انتشار الفيروس المسبب لهذا المرض. وقالت المنظمة، إن 3 مليارات و200 مليون شخص دون سن الخمسين يعانون من فيروس "هربس سيمبلكس"، النوع الأول، والذي يسبب ظهور تقرحات في الفم.. فيما يزيد مرض الهربس من النوع الثاني من مخاطر الإصابة وانتشار فيروس مرض الايدز، رغم أن العلاقة بين المرضين ما زالت غير معروفة حتى الآن.
346
| 29 أكتوبر 2015

ارتفع استهلاك القهوة حول العالم بشكل ملحوظ، حيث بلغ الضعف خلال 20 عاما، حسبما أعلن مدير المنظمة الدولية للقهوة روبيرو أوليفيرا. وقال أوليفيرا بالتزامن مع افتتاح المعرض الثامن للقهوة الذي عقد قبل أيام في بوجوتا "لم يبلغ استهلاك القهوة في العالم الحد الذي بلغه في السنوات العشرين الماضية، وقد سُجل ارتفاع في الاستهلاك بنسبة الضعف". ورغم الأمطار الغزيرة التي هطلت في البرازيل أول منتج للبن في العالم، والجفاف في كولومبيا، والأمراض التي تضرب مزارع البن في عدد من دول أمريكا الوسطى، فإن أوليفيرا يبدو متفائلا حول مستقبل إنتاج القهوة في العالم، ولا سيما بفضل الطلب المتنامي بنسبة 2.5% سنويا. ويعود الارتفاع في الطلب إلى النمو السكاني من جهة، وإلى نمو الإقبال على القهوة من جهة أخرى، بحسب أوليفيرا الذي يتوقع ارتفاعا في الطلب في السنوات العشر المقبلة قدره 25 مليون كيس، علما بأن الكيس الواحد يحتوي على ستين كيلوغراما. وأنشئت المنظمة الدولية للقهوة في لندن العام 1963، تحت رعاية الأمم المتحدة، وهي تضم الدول المستوردة والمصدرة للقهوة، بهدف التعاون على مواجهة المشكلات التي قد تضرب القطاع. وتشكل الدول الأعضاء في المنظمة 95% من إنتاج القهوة في العالم و83% من الاستهلاك، بحسب البيانات المنشورة على موقع المنظمة على شبكة الإنترنت.
778
| 26 أكتوبر 2015

يعد الكرنب الأحمر، منجماً للفيتامينات، لاسيما "ج" و"ك"، وذلك حسبما قال المركز الألماني لاستعلامات المستهلك. وأوضح المركز الألماني، أن 200 جرام من الكرنب الأحمر تحتوي على 400% من الاحتياج اليومي للجسم من فيتامين "ك"، والمفيد لتخثر الدم مثلاً. كما يزخر الكرنب الأحمر أيضاً بالمواد النباتية الثانوية، مثل الانثوسيانين والفلافونويد والكلوروفيل والاندول والفينول، والتي تحمي الجسم من المواد الضارة. وبالإضافة إلى ذلك، يعتبر الكرنب الأحمر من المصادر الغنية بالألياف الغذائية، التي تمنح إحساساً بالشبع لفترة أطول وتحفز عملية الأيض.
741
| 25 أكتوبر 2015

تمثل اللحوم المصنعة، كالبرجر والنقانق واللحم المقدد، تهديداً كبيراً للإصابة بمرض السرطان، مشيرةً إلى أن خطورتها لا تقل عن التدخين، وذلك حسبما ذكرت منظمة الصحة العالمية. كما ينضم اللحم الأحمر الطازج إلى قائمة المواد المسببة للسرطان، وإن بدرجة أقل من اللحوم المصنعة والمضاف إليها مواد حافظة. وبحسب صحيفة "ديلي ميل" البريطانية، فإن سرطان الأمعاء يعدُّ ثاني أكثر الأمراض القاتلة في بريطانيا، وتشير التقديرات إلى أن نصف الحالات يمكن تجنبها باتباع أسلوب حياة صحي. واختتمت الصحة العالمية تقريرها بأن اللحوم المصنعة "على الأرجح" قد تزيد من احتمالات الإصابة بسرطان الأمعاء، بل من المتوقع أن تذهب إلى أبعد من ذلك بالجزم بأنها تسبب السرطان. وتشير تقارير الصحة العالمية، إلى أن التدخين أحد أهم 5 أسباب للإصابة بالأورام الخبيثة، بحيث يمكن أن تتقاسم اللحوم المصنعة الخطورة مع السجائر والكحول والزرنيخ والاسبتسوس. وتشمل اللحوم المصنعة النقانق واللحم المقدد والبسطرمة والسلامي والهوت دوج، وربما ينضم البرجر إلى القائمة أيضاً، حيث يتم تصنيع تلك المواد عن طريق التمليح أو التدخين أو المعالجة بإضافة مواد كيميائية. واللحوم الحمراء بشكل عام تحتوي على تركيزات عالية من الدهون ويعتقد أن المركب الذي يمنح اللحم اللون الأحمر هو المسؤول عن تلف بطانة الأمعاء. وتتسبب اللحوم المصنعة في وفاة واحد من كل 30 حالة وفاة وذلك بسبب المواد الكيميائية المستخدمة في تصنيعها. وينصح الباحثون بأنه إذا تم تقليل كمية اللحوم الحمراء المستهلكة يومياً إلى 20 غرام، فإن يمكن منع تعرض 20 ألف حالة وفاة مبكرة في المملكة المتحدة سنوياً. أما عن الجانب التجاري، فقد تؤدي نتائج ذلك التقرير إلى انخفاض مبيعات اللحوم المصنعة على مستوى العالم، كما حدث بالعام الماضي، حينما أصدرت المنظمة تقريراً يحذر من الاستهلاك المفرط للسكر. وينصح الباحثون بألا يتناول البالغون أكثر من 70 جراماً من اللحوم الحمراء يومياً، كما ينصح الصندوق الدولي لأبحاث السرطان تجنب تناول اللحوم المصنعة تماماً.
1172
| 25 أكتوبر 2015

الخمول والكسل والشعور بالإعياء من الاضطرابات الشائعة للغاية، والتي يشعر بها الكثير من الموظفين والطلاب والناس بصفة عامة، وغالباً ما نعجز عن تحديد أسباب هذه الأحاسيس السلبية. ونسلط الضوء خلال التقرير التالي على أبرز الأسباب غير المتوقعة التي تؤدى للشعور بالخمول واستنفاذ الطاقة وعدم القدرة على أداء الأعمال المطلوبة، وذلك حسبما نشر على الموقع الإلكتروني لصحيفة "ديلى ميل" البريطانية، وتشمل. 1- الأنيميا من أكثر الأسباب المؤدية للإصابة بالكسل والخمول والدوخة، بغض النظر عن عدد الساعات التي نمتها أو الطعام الذي تناولته، ولذا يجب علاجها سريعاً تحت إشراف الطبيب. 2- ممارسة الرياضة ممارسة الأنشطة البدنية قبل النوم مباشرة يرفع مستوى الأدرينالين ومعدلات التنفس وضربات القلب، وهو ما يجعلك غير قادر على النوم، وكما يحظر الإفراط في ممارسة الرياضة، لأن تأثيرها سيكون سلبياً، ولذا ينصح بممارسة الرياضة بقدر متوسط خلال الصباح. 3- الاكتئاب قد تكون مصاباً بالاكتئاب، ويصاحب ذلك غالباً الشعور بالإعياء، مع ضعف الحافز في الحياة وانخفاض الرغبة الجنسية، ولذا ينصح بتناول الأطعمة الصحية، والأكلات التي تحسن المزاج مثل الشيكولاتة، مع ممارسة الرياضة بانتظام في الهواء الطلق. 4- قد تكون مصابا بمرض السكر أو مشاكل في مستويات سكر الدم، حيث ترتفع مستويات السكر في دمك بشكل ملحوظ، ولا يستطيع جسمك الاستفادة منها، ولا يحولها إلى طاقة، وبالتالي تصاب بالخمول والكسل، ولذا يجب قياس سكر دم عشوائي، وإطلاع الطبيب على النتائج. 5- عدم تناول القدر الكافي من المياه يجعلك تشعر بالخمول والكسل والإعياء، لذا تناول 2 لتراً من المياه على الأقل خلال اليوم. 6- نقص فيتامين "ب 12" إذا كنت تشعر بالإعياء رغم تناول الطعام الصحي، فذلك قد يكون دلالة على معاناتك من نقص مستويات فيتامين "ب 12" في الدم، وهو يساهم في حمل الأكسجين عبر الجسم كله، ومهم جداً لتعزيز مستويات الطاقة والنشاط في الجسم، ولذا يجب إجراء اختبار مستويات هذه الفيتامين بعد استشارة الطبيب، والحصول على كبسولات أو حقن فيتامين "ب 12" إن لزم الأمر. 7- اضطرابات النوم وعدم الحصول على القدر الكافي منه، يساهم على المدى البعيد في الشعور باستنفاذ الطاقة. 8- نقص معدلات إفراز هرمون النشاط من الغدة الدرقية يساهم في الشعور بالخمول والإعياء، ولذا يمكنك إجراء اختبار هرمونات الغدة بعد استشارة الطبيب، وخاصة ً إذا كنت لا تعانى من أي أمراض أخرى. 9- الوجبات الثقيلة الغنية بالدهون والسكريات مثل تناول سندوتشات الجبنة مع قالب من الشيكولاتة يساهم في استنفاذ قدر أكبر من الطاقة التي ستمنحها هذه الأكلات لجسمك، ولذا يجب تناول أكلات خفيفة ومضغها جيداً والابتعاد عن الطعام غير الصحي.
2239
| 24 أكتوبر 2015

هل تفضلون الطعم الحلو أم المرّ؟ الإجابة على هذا التساؤل مهمة لأنها تدل على صفات سلبية في الشخصية. فوفقا لدراستين حديثتين توصل الباحثون إلى أن الأشخاص الذين يفضلون الطعم المرّ يتسمون بسمات سلبية. فما هي هذه السمات؟ الميل لشرب القهوة بدون سكر أو تناول شيء مر بدلا من قطعة الحلوى، يعني تفضيل الطعم المرّ على الحلو. وهذا ربما يُفصح عن بعض الصفات الشخصية للكثيرين. ففي دراستين قام بهما باحثون في جامعة "انسبروك" النمساوية، أكد الباحثون أن الشخص الذي يفضل الطعم المرّ يتسم بسمات عدوانية. وتوصل الباحثون إلى هذه النتيجة عبر استجواب لحوالي 950 شخصا شاركوا في هذه الدراسة. ونشر الباحثون نتائج دراستهم في دورية "شهية" النمساوية، مشيرين إلى أن تفضيل الطعم المرّ يرتبط بشكل وثيق بسمات الشخصية السادية والسيكوباتية، وهي صفة تدل على وجود خلل في السلوك والمشاعر. وأكد الباحثون أن هذا الارتباط ظهر بشكل أقوى من تفضيل مذاق آخر مثل الحلو والحامض والمالح. كما أشارت الدراسة إلى أن سمات الشخصية الباطنية ترتبط بشكل مطرد مع شدة الطعم المر. ووفقا لموقع "ناخريشتن" الألماني، فإن العلاقة التي تربط تفضيل الطعم المرّ بالسيكوباتية ربما تكون مؤكدة إحصائيا. لكن نتائج الدراسة أظهرت أن نسبة هؤلاء الأشخاص الذين يتسمون بشخصية سيوكوباتية ويفضلون الطعم المرّ لم تتجاوزالـ5 بالمئة، على حدّ اعتبار البروفوسور نيلز بيرباومر أستاذ علم النفس الطبي والسلوكي في جامعة توبنجن. وفي حديث لها مع موقع "فوكوس" الألماني، أوضحت الباحثة كريستينا زاغيوغلو، المشرفة على هذا البحث، أن هذه الدراسة لا ترتبط باضطرابات نفسية مرضية. فقيم الأشخاص الذين تم اختبارهم كانت كلها منخفضة، ولكنها تشير بوضوح إلى أن عشاق الطعم المرّ يمليون إلى سلوكيات الشخصية السيكوباتية. وفي الجزء الأول من الاختبار قام الباحثون بتقديم لائحة مؤلفة من 40 نوع من الأطعمة بمذاقات مختلفة، مثل الحلوى والليمون والفجل وأنواع مختلفة من اللحوم. وتوجب على المشاركين في التجربة تقيم مدى تفضيلهم لمذاق هذه الأطعمة. واعتمد الباحثون في تقييمهم على نتائج تصنيف الأطعمة وفقا لإجابات المشاركين في التجربة، كما أظهر المشاركون مدى تفضيلهم للطعم الحلو والمالح والمرّ والحامض. عوامل أخرى تؤثر على الشخصية وقام المشاركون بملء بيانات شخصية مختلفة، لقياس مستوى العدوانية التي يتسم بها الأشخاص. وذلك من خلال الإجابة على بعض الاستفسارات التي تقدر مدى استخدامهم لتعابير مثل "هددت أشخاصا أعرفهم" أو "الاستفزاز يدفعني لأن أضرب شخص ما"، فضلا عن الإجابة عن تساؤلات ترتبط بصفات مثل النرجسية والسادية والسيكوباتية مثل: "يسعدني تعذيب الآخرين". كما قيم الباحثون شخصية المشاركين من خلال عناصر الشخصية الخمسة وهي الأبعاد التي تكّون شخصية الإنسان، وهذه العناصر الانفتاح والضمير والمخالطة والقدرة على التحمل والاضطراب. وجدير بالذكر أن نتائج الدراسة الثانية التي أقيمت في هذا الإطار، تطابقت إلى حد كبير مع الأولى. واعتمدت كلا التجربتين على تقديرات المشاركين الشخصية ونتائج الإحصاءات التي تربط علاقة الشخصية بالذوق. وفي كلتا الدراستين أكد الباحثون أن هذه العلاقة ترتبط بعوامل كثيرة منها تفاعل المورثات الجينية مع بعضها.
743
| 24 أكتوبر 2015

يعاني الكثير من الموظفين في سوق العمل الحالي من مشكلة ضغط العمل، والذي غالباً ما ينشأ عن مجموعة من العوامل التي تشمل ساعات العمل الطويلة، وزيادة المسؤوليات والمهل القصيرة لتسليم المشاريع. ولحل هذه المشكلة يقدم لك الخبراء، بعض النصائح لمساعدتك على تجنب العمل لساعات إضافية دون التأثير على إنتاجيتك: إعداد لائحة بمهام عملك معظم الأشخاص يتمتعون بمستوى عالٍ من الإنتاجية خلال الساعات الأولى في العمل، لذا احرص على انجاز أكثر المهام أهمية في الصباح وقم بتأجيل المهام البسيطة إلى نهاية يومك في العمل، بهذه الطريقة فإنك لن تشعر بالتوتر بشأن المشاريع المهمة في نهاية اليوم. رفض المهام عند الضرورة اكتشف كَم العمل الذي يمكنك تحمّله والتزم به، وارفض القيام بالمزيد من المهام، ندرك أنه ليس من السهل رفض القيام بالمهام التي يوكلها إليك مدير عملك، فقد تظن بأن ذلك سيترك انطباعاً سيئاً عن شخصيتك ويقلل فرص حصولك على ترقية، ولكن في الحقيقة، يقدّر المدراء ظروف موظفيهم ويحترمون آرائهم وقراراتهم، فلا تتردد في التعبير عن رأيك. التحدث إلى مديرك تذكر أن التواصل هو من أسس تحقيق السعادة، وبخاصة في العمل، فإن كنت تضطر يومياً للعمل لساعات متأخرة، تحدّث بصراحة مع مديرك واقترح الاستعانة بشخص آخر لمساعدتك على إتمام المهام الإضافية. أخذ فترات من الراحة يتعين عليك أخذ فترات استراحة بين الحين والآخر لاستعادة نشاطك وحيويتك، فهذه هي أفضل وسيلة للتخلص من التوتر المسيطر عليك، في الواقع، يمكنك استخدام فترات الراحة لمكافأة نفسك عند انتهائك من إتمام مهمة ما، سيساعدك ذلك على الحفاظ على مستوى عالٍ من الإنتاجية والحماس في العمل. تجنب اللهو على شبكة الانترنت مواقع التواصل الاجتماعي هي من أهم مصادر اللهو في العمل، تذكر أن قضاء وقت كبير في تصفح مواقع التواصل الاجتماعي لن يؤثر سلباً على مستوى تركيزك فحسب، بل سيخفّض أيضاً من إنتاجيتك، لذا احرص على تخصيص وقت معين لتصفح شبكة الإنترنت يومياً. القيام بالأمور التي تساعدك على الاسترخاء يمكنك مثلاً ممارسة هواياتك المفضلة أو الاستماع إلى الموسيقى، كما يعد ممارسة التمارين الرياضية بانتظام وسيلة متميزة لتعزيز مستوى تركيزك ونشاطك.
318
| 23 أكتوبر 2015

تمكن فريق من المختصون الأمريكيون بتجربة كبيرة من التحقق من وجود علاقة متبادلة بين الزيادة في وزن الإنسان وظهور الأمراض السرطانية لديه. وخلصت التجربة إلى أن أفضل طريقة للوقاية من الأورام السرطانية تتلخص في التخلص من الوزن الزائد. شارك في التجربة الأمريكية المذكورة أعلاه 5 ملايين شخص، حيث بينت نتائج الدراسة أن سبب ظهور أكثر من 12 ألف إصابة جديدة بالسرطان في بريطانيا يعود إلى الوزن الزائد. كما اتضح أن الزيادة في مؤشر كتلة الجسم بمقدار 5 نقاط يزيد من احتمال الإصابة بسرطان الرحم بنسبة 62% وبسرطان الكلى بنسبة 25%. وقد أجرى العلماء تجربة على الفئران تم خلالها تقديم طعام بسعرات حرارية أقل من المعتاد، مما أدى إلى انخفاض وزنها، وانخفض، بالتالي، عدد الإصابات بسرطان الثدي بين الإناث منها، أما الرجل البدين فقد يتعرض لسرطان القولون، والوزن الزائد لديه يكون حافزا لذلك. وخرج العلماء بالاستنتاج التالي: يجب على المرء مراقبة وزن جسمه لتجنب خطر الإصابة بالسرطان.
367
| 21 أكتوبر 2015

من الممكن أن ينتقل طفيل الملاريا المقاوم للعقاقير، والذي اكتشف في جنوب شرق آسيا، إلى سلالات البعوض في إفريقيا، وحذرت دراسة حديثة من أن عواقب هذا الأمر ستكون وخيمة وتعرض حياة الملايين للخطر. وقال الدكتور ريك فيرهيرست من المعهد الوطني للحساسية والأمراض المعدية "NIAID" الذي أجرى البحث "نعتقد أن ذلك سيوفر دفعة إضافية لتكثيف الجهود المبذولة للقضاء على الملاريا في جنوب شرق آسيا". واكتشفت هذه النوعية من المرض الطفيلي للمرة الأولى في كمبوديا عام 2008، وهذه العدوى تقاوم بشدة عقار أرتيميسينين، وهو العقار الرئيسي لمكافحة الملاريا. وليست هذه المرة الأولى لفقدان فاعلية هذا العقار فمنذ خمسينات القرن الماضي بدأت العديد من العقاقير تفقد فاعليتها في مكافحة طفيل الملاريا مع تطوره باستمرار، وفي كل مرة ظهرت هذه المشكلة في المنطقة الحدودية بين تايلاند وكمبوديا قبل أن تنتشر إلى باقي العالم.
376
| 21 أكتوبر 2015

كشفت دراسة طبية حديثة أشرف عليها باحثون من جامعة جنيف السويسرية، عن أن صعود السلالم بدلاً من ركوب المصعد يساهم في خفض مستويات الكولسترول المرتفع بالدم. وشملت الدراسة 67 شخصًا، قاموا بالصعود على السلالم داخل مقر عملهم ولم يستخدموا المصعد إطلاقاً لمدة 3 شهور. وكشفت النتائج عن أن الصعود على الدرج يساعد في خفض أحد البروتينات التي تعرقل تخلص الكبد من الكولسترول، وهو ما يساهم في خفض مستويات الكولسترول الضار "ldl" بالدم. ولم يفسر الباحثون السبب وراء فاعلية الرياضة في خفض الكولسترول، وأكدوا أن تلك تعد الدراسة الأولى من نوعها التي تثبت أن الرياضة وتغيير أسلوب الحياة يساهم في خفض الكولسترول بالدم. ونشرت هذه النتائج بالمجلة الطبية "European Journal of Clinical Investigation"، وكما نشرت على الموقع الإلكتروني لصحيفة "ديلي ميل" البريطانية، في العشرين من شهر أكتوبر الجاري.
1657
| 20 أكتوبر 2015

قد تكون سمعت أن الجزر والمأكولات البرتقالية اللون والخضار تساعد على حماية النظر وذلك بسبب احتوائها على مادة البيتاكاروتين، أي نوع من فيتامين "أ" يعطي هذه الأطعمة لونها البرتقالي، ولكن ليست مادة البيتا كاروتين هي فقط التي تحسن النظر، بل هناك أيضاَ معادن أخرى وفيتامينات جيدة للنظر، مثل هذه الأطعمة التي تحافظ على صحة العين وتقوي النظر: الخضار الورقية: تحتوي الخضار الورقية على مواد مضادة للأكسدة مثل لوتين وزياكسانثين، والتي تؤدي إلى انخفاض خطر الإصابة بالضمور البقعي وتحسين النظر. البيض: يُعتبر صفار البيض مصدر رئيسي للمواد المضادة للأكسدة مثل لوتين وزياكسانثين بالإضافة إلى الزنك، وكل هذه العناصر تساعد على تقليل خطر الضمور البقعي الخاص. التوت والحمضيات: هذه الثمار غنية بالفيتامين C، والذي أثبت قدرته على الحد من خطر الإصابة بالضمور البقعي ضعف عدسة العين. اللوز: يعتبر اللوز غنياً بالفيتامين E، الذي يؤدي إلى إبطاء الضمور البقعي. الأسماك الدهنية: سمك التونة والسلمون والماكريل والأنشوجة وسمك السلمون المرقط، كل هذه الأسماك غنية بالأحماض الدهنية الموجودة في شبكية العين، والتي يؤدي النقص بها إلى الإصابة بمتلازمة جفاف العين.
337
| 19 أكتوبر 2015
كشفت دراسة علمية حديثة عن وجود ملايين من البكتيريا الخطيرة للغاية قد تنتقل في أكثر من منطقة غير صحية في أماكن العمل، مثل الأسطح وهاتف المكتب وشاشة الهاتف المحمول والكيبورد. ووجد الباحثون من جامعة كوينزلاند صورا مروعة من البكتيريا الموجودة على جميع أنحاء المكتب، وعلى مقابض الأبواب والمكاتب والكراسي. وقال كبير الباحثين الدكتور داى كوبر من مركز كوينزلاند في أستراليا، إن أفضل طريقة لتجنب البكتيريا من خلال استخدام الصابون والماء بدلا من استخدام سائل مضاد للبكتيريا. وأوضح كوبر أن الصابون والماء هو حل عملي ورخيص وأكثر فعالية إذا أردنا رفع مستوى الوعي، حيث إن هناك بكتيريا في كل مكان، والكثير من المواد المعقمة لليدين قد تكون غير متوفرة دائماً في العمل. وعلى الرغم من أن العديد من المنظفات قد تستخدم شعار "يقتل 99.9% من الجراثيم"، إلا أنه مجرد شعار، وفقا لــ"كوبر".
1419
| 19 أكتوبر 2015

تداول مستخدمو موقع التواصل الاجتماعي "فيسبوك"، مقطع فيديو لطريقة بسيطة لعمل عصير البطيخ دون الحاجة لفتح الثمرة أو تقطيعها، ودون استخدام الخلاط. ويظهر في الفيديو شخص يقطع جزءا من الثمرة ثم يضع جهاز العصر بداخلها، ومن ثم يقوم بصب العصير في الكوب بكل سهولة.
2000
| 19 أكتوبر 2015

تبدأ إنتاجية الشخص وقدرته على التفكير بالانخفاض بعد مضي أسبوع واحد فقط من البدء بتقليل النوم، حسبما بينت نتائج دراسة علمية مكرسة لتحديد خطورة قلة النوم على الصحة. ولا يدرك العديد من الناس أن جسمهم يعاني من قلة النوم، وإن التغيرات السلبية التي يشعر بها الشخص هي إشارات لنا تعلمنا بأن الجسم يعاني من قلة النوم، إلا أننا نعتبرها أعراضا لأمراض أخرى. وللتخلص من هذه الأعراض وضع العلماء قائمة بهذه الإشارات التي تعلم الإنسان بأنه على عتبة مشاكل صحية، لذلك ينصحون بضرورة الانتباه إلى هذه الأعراض دائما، ومن هذه الأغراض انخفاض إنتاجية العمل الناتجة عن عدم القدرة على التركيز في تنفيذ العمل اليومي المعتاد. وضعف الذاكرة، الكآبة، والتهيج والعصبية والقلق وعدم القدرة على تجاوز المواقف العصيبة، بالإضافة إلى مشاكل في البصر يرافقها الشعور بعدم وضوح الصورة "ضبابية وغير ثابتة". كما تنتج مشاكل في النطق، مثل البحث عن الكلمة المناسبة خلال الحديث والارتباك وغيرها تشير إلى وجود مشاكل في خلايا الدماغ ناتجة عن قلة النوم، تسبب خلل في وظيفة التفكير. ومن الأعراض الناتجة عن قلة ساعات النوم زيادة الشهية، التي يحفزها هرمون التوتر النفسي "كورتيزول"، الذي يرتفع مستواه في الجسم. وينصح الخبراء، بضرورة مراجعة الطبيب عند الشعور بهذه الأعراض، لأنه حسب قولهم قلة النوم تسبب قصر العمر، نتيجة التغيرات السلبية في عمل منظومة المناعة والقلب والأوعية الدموية وعمل منظومة الغدد الصماء.
480
| 19 أكتوبر 2015

قد يتجاهل الكثيرون بعض الإشارات والتغيرات التي تطرأ على أجسادهم، وذلك بسبب بساطتها الظاهرية، لكن حذر كثير من الأطباء من هذا التجاهل ونبهوا بضرورة الاهتمام حال ظهور واحدة أو أكثر من هذه الإشارات لأنها قد تكون رسالة استغاثة من الجسد يخطر خلالها بتعرضه لمكروه ما. ونشر موقع "ناتشرال هيلث كير" مجموعة من الإشارات التي يبعث بها الجسد إذا أصابته علة ما، وفيما يلي الإشارات الأكثر شيوعًا: 1- الشامة الشامات في معظمها لا ضرر من وراءها، لكن حال ظهورها جراء التعرض لـ"حمام شمس" فإنها قد تكون خطيرة. 2- الشعر الأشيب قبل بلوغ الـ40 اكتساء أكثر من 50% من شعر الإنسان باللون الأبيض قبل بلوغ الـ40، مع عدم وجود سوابق في تاريخ العائلة قد تشير إلى الإصابة بمرض السكري. 3- تشقق الشفاه قد ينتج تشقق الشفاه عن تغير درجات الحرارة أو التعرض لرياح، لكنه إذا تكرر كثيرًا، فإنه قد يكون نتاجًا لعدوى فطرية أو نقص فيتامين "ب". 4- انتفاخ الرقبة هذه واحدة من الإشارات التي يجب التوجه إلى الطبيب فور ظهورها، أما السبب الأكثر شيوعًا وراء انتفاخ الرقبة فهو عدم عمل الغدة الدرقية بصورة طبيعية، وغالبًا ما يحدث هذا لنساء بين الـ20 والـ50 من العمر. 5- تغير لون بياض العين يجب أن يكون "بياض العين" أبيض دومًا، إلا في حالات نقص النوم أو التعرض لنزلة برد، وعند تحول اللون إلى الأصفر، فإن هذا قد ينبئ عن مشكلات تتعلق بالصفرة أو الكبد، أما إذا تحول "بياض العين" إلى اللون الأحمر، فهذا يعني إما ارتفاع ضغط الدم أو الإصابة بمرض فيروسي. 6- احمرار راحة اليد قد يكون احمرار راحة اليد مؤشرًا على الإصابة بإكزيما أو التهاب الجلد أو حساسية، كما أنها قد تكون مؤشرًا على تعرض الجسد لإنهاك أو تعرض الكبد لمرض ما. 7- تساقط شعر الحواجب يمكن أن يكون التساقط المفاجئ لشعر الحاجب مؤشرًا على مشكلات تتعلق بالغدة الدرقية أو قصور الدرقية. 8- تغير الأظافر تبدل شكل الأظافر إلى صورة مشققة وهزيلة قد يكون وراءه أسباب جينية، أو قد ينبئ عن نقص الكالسيوم أو خلل في عمل الغدة الدرقية.
554
| 19 أكتوبر 2015
مساحة إعلانية
الأكثر مشاهدة

يدخل منتخب مصر الجولة الثالثة والأخيرة من منافسات المجموعة السابعة في كأس العالم 2026 وهو في صدارة الترتيب برصيد 4 نقاط، متقدمًا على...
9768
| 26 يونيو 2026

مع عودة موسم السفر والطيران بقوة خلال العطلات الصيفية، واستقبال المطارات لمئات المسافرين يومياً، يوفر مطار حمد الدولي بصفته أفضل مطارات العالم، مجموعة...
8784
| 27 يونيو 2026

أوضحت وزارة الداخلية أنه في إطار إجراءات التدقيق والمتابعة الروتينية للوسائط البحرية والتي تضطلع بها الإدارة العامة لأمن السواحل والحدود، تبين تأخر إحدى...
6498
| 28 يونيو 2026

حمل تطبيق الشرق
تابع الأخبار المحلية والعالمية من خلال تطبيقات الجوال المتاحة على متجر جوجل ومتجر آبل
الأكثر رواجاً
- 1 إبراهيموفيتش يهاجم حكم مباراة مصر وإيران: سرقتم حلم أمة بأكملها
هاجم النجم السويدي المعتزل زلاتان إبراهيموفيتش، قرار إلغاء هدف منتخب إيران في الوقت بدل الضائع أمام منتخب مصر لكرة القدم، ضمن الجولة الثالثة...
4406
| 27 يونيو 2026
- 2 د. رانية محمد: 2400 مقعد بقيمة القسيمة التعليمية للقطريين بالمدارس الخاصة
- 9000 مقعد تعليمي ضمن مشروع المسؤولية المجتمعية حتى الآن - احتساب إجمالي دخل الأسرة بعد خصم جميع الالتزامات المالية أكدت الدكتورة رانية...
3806
| 26 يونيو 2026
- 3 الجريدة الرسمية: غرامات حتى 25 ألف ريال على مخالفات مكاتب الاستقدام
أصدر حضرة صاحب السمو الشيخ تميم بن حمد آل ثاني أمير البلاد المفدى، القانون رقم (9) لسنة 2026 بتعديل بعض أحكام قانون العمل...
2136
| 26 يونيو 2026



